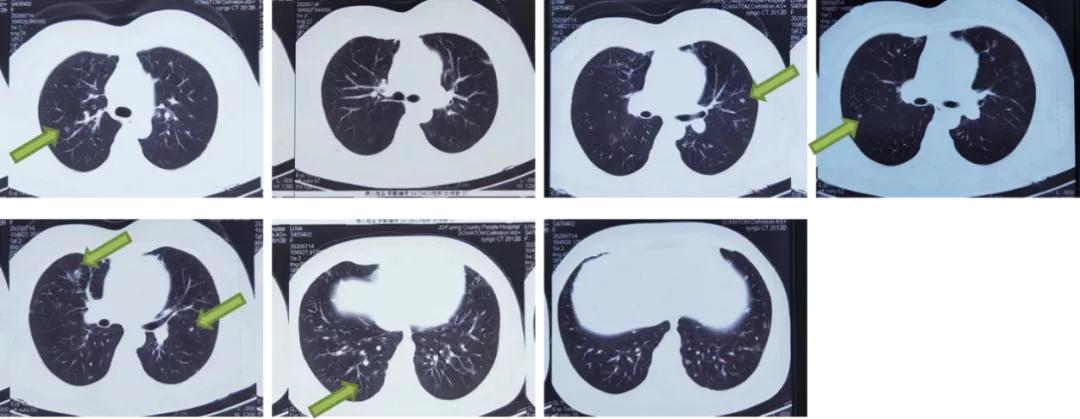
双肺多发结节，反复检查为何诊断重点成「盲区」？

引言
从该案例纷繁复杂的检查过程一窥究竟,临床诊断与鉴别诊断中我们欠缺的思考究竟是什么?为什么会遗漏重点,变成一个「盲区」?遗传因素和免疫缺陷导致的肺部肉芽肿疾病一直是个被忽视的角落。通过本案例想提示同道,肺部病变是多种全身性疾病在人体中的「窗口」,如结缔组织疾病、血管炎、IgG4相关性疾病等。而呼吸科医生对原因不明的肺部病变,在诊疗过程中不能仅仅着眼于肺部病变,需要纵观全局,开放思维跳出局限,不放过任何一条异常的检查结果,全面而细致的查体和询问病史才能给我们带来更多线索。
体检双肺多发结节,患者自购中药服用病灶有所吸收,却因一次受凉病情加重……BALF高通量测序和病理发现什么?
患者为一名37岁的女教师,2020年11月8日主诉 「体检发现双肺多发结节半年余,咳嗽1月」 入住我院。患者于2020年4月28日于当地医院体检时查胸部CT见两肺多发结节(最大直径0.8cm),性质待定;纵隔小淋巴结,两肺局部少许炎症,无咳嗽咳痰,无胸闷气急,未予治疗。2020年5月9日,患者至上海市某三甲医院就诊,行支气管镜检查提示未见新生物。于右肺中叶内侧段行灌洗,BALF送检高通量测序结果回报不动杆菌、大肠埃希菌、金黄色葡萄球菌、假单胞菌、结膜干燥棒状杆菌、粪场球菌、粪产碱杆菌。于右肺上叶后段行TBLB及刷检,病理及脱落细胞学提示慢性炎症改变、未见恶性肿瘤细胞,未予治疗。
2020年6月份,患者自购中药(具体不详),共计服用1月余,7月14日于当地医院复查胸部CT结果示两肺多发结节,较2020年4月28日有所吸收,纵隔、双侧腋窝小淋巴结;双肺局部少许炎症;脾大,肝内致密影。期间无不适,未予治疗。2020年8月27日,患者再次于当地医院复查胸部CT示两肺多发结节、絮状影,病灶较7月14日相仿;纵隔、双侧腋窝小淋巴结。
2020年10月期间,患者一次受凉后出现咳嗽、咳痰,痰色黄白,量较多,易咳出,无胸闷气急,无头晕头疼。11月2日至当地医院行胸部CT结果示两肺多发结节、絮状影,较8月27日相比片病灶增多、增大;纵隔、双侧腋窝小淋巴结;两肺局部少许炎症。当地医院建议患者至上级医院进一步诊治。11月4日,患者至我院就诊,行胸部CT平扫+增强三维示双肺多发结节,突出病灶位于右肺下叶外基底段和左肺下叶前基底段;纵隔淋巴结肿大;肝脏钙化灶;右肾结石;脾大。为进一步诊治,门诊以「肺结节」收入院。患者自患病以来,精神状态良好,体重无明显变化,饮食正常,二便正常,睡眠无异常。
追问病史发现,该患者于2020年8月曾感染带状疱疹,外院规范使用静脉药物及外用药治疗后改善(具体不详),现右前胸壁、右臂屈面、右肩背部可见带状疱疹后多发瘢痕(长约2*2cm,高于皮面,无触痛)。否认高血压病史、糖尿病史、冠心病史,否认结核、肝炎等传染病史,否认外伤史、手术史、输血史,主诉造影剂过敏。患者久居原籍,否认疫水接触史;无吸烟史;无饮酒史;预防接种史随当地。已婚,配偶体健。生育史:2-0-0-2,2子均体健。家族史:父母及妹妹均体健,否认家族遗传病史。
入院查体情况为:体温 36.2℃ 脉搏 72次/分 呼吸 18次/分 血压 122/76 mmHg。患者一般情况尚可,神志清楚,精神尚可,生命体征平稳,浅表淋巴结未及肿大。右前胸壁、右臂屈面、右肩背部可见带状疱疹后多发瘢痕(长约2*2cm,高于皮面,无触痛)。双肺呼吸音清,未及干湿啰音。脾脏肋下可触及,质软,余心、腹及神经系统未及异常,双下肢无水肿。

图1:患者右前胸壁、右肩背部、右臂屈面带状疱疹后残留瘢痕
患者2020年在外院实验室及辅助检查情况如下:
4月28日行胸部CT显示两肺多发结节(最大直径0.8cm),性质待定;纵隔小淋巴结,两肺局部少许炎症。

图2:胸部CT(2020.4.28)
5月7日于上海市某三甲医院查血常规:白细胞:4.47×10^9/L、中性粒细胞%:67.1%、淋巴细胞%:19.3%↓、单核细胞%:11.0%↑、嗜酸性粒细胞%:2.3%、嗜碱性粒细胞%:0.3%、中性粒细胞:2.7×10^9/L、淋巴细胞:0.8×10^9/L↓、单核细胞:0.44×10^9/L、嗜酸性粒细胞:0.09×10^9/L、嗜碱性粒细胞:0.01×10^9/L、红细胞:4.47×10^12/L、血红蛋白:128g/L、血小板:113×10^9/L↓;5月8日的血检验情况为:免疫球蛋白G4 0.05g/L。呼吸道常见病原体九项 阴性。抗核抗体、抗双链DNA抗体、抗核小体抗体、抗线粒体抗体、抗平滑肌抗体、抗心磷脂抗体、ANCA、抗CCP抗体、抗「O」、类风湿因子、高敏感C反应蛋白 阴性;5月9日的支气管镜检查结果:未见新生物。

从左至右:隆突、右主支气管、右中间支气管

从左至右:左主支气管、左肺上叶支气管、左肺下叶支气管
图3:支气管镜检查(2020.05.09)
5月9日的病理回报显示:(右肺上叶后段病灶支气管镜活检)送检活检活组织肺泡间隔增宽,胶原纤维组织增生,间质少量淋巴细胞浸润,符合慢性炎症改变;11日的脱落细胞学报告显示:(右肺上叶后段支气管镜刷检)目前未见明确的恶性肿瘤细胞。
5月10日对「右肺中叶内侧段」BALF高通量测序结果显示:细菌:不动杆菌(Reads=2478),大肠埃希菌(Reads=932),金黄色葡萄球菌(Reads=800),假单胞菌(Reads=500),结膜干燥棒状杆菌(Reads=153),粪场球菌(Reads=52),粪产碱杆菌(Reads=43)。
7月14日,患者于当地医院行胸部CT显示两肺多发结节,较4月28日相比有所吸收;纵隔、双侧腋窝小淋巴结;双肺局部少许炎症;脾大,肝内致密影。
图4:胸部CT(2020.07.14)
8月27日于当地医院行胸部CT显示两肺多发结节、絮状影,性质待定,病灶较7月14日相仿;纵隔、双侧腋窝小淋巴结。

图5:胸部CT(2020.08.27)
11月2日于当地医院做血常规检查:白细胞:3.05×10^9/L↓、中性粒细胞%:62.60%、淋巴细胞%:26.60%、单核细胞%:7.20%、嗜酸性粒细胞%:3.30%、嗜碱性粒细胞%:0.3%、中性粒细胞:1.91×10^9/L、淋巴细胞:0.81×10^9/L↓、单核细胞:0.22×10^9/L、嗜酸性粒细胞:0.10×10^9/L、嗜碱性粒细胞:0.01×10^9/L、红细胞:4.27×10^12/L↓、血红蛋白:112g/L↓、血小板:81×10^9/L↓。
同日,行胸部CT显示:两肺多发结节、絮状影,性质待定,较8月27日(影像)片病灶增多、增大;纵隔、双侧腋窝小淋巴结;两肺局部少许炎症。

图6:胸部CT(2020.11.02)
从院内实验室及辅助检查能否判定患者双肺多发结节样病变原因?还应完善哪些检查?根据院内临床表现诊断方向在哪?
针对患者在外院的检查情况进行综合分析,团队认为,该患者体检发现双肺结节样病变,半年来双肺病灶缓慢进展,咳嗽、咳痰症状不显著,无发热、盗汗、消瘦,无胸闷、气促,无皮肤(除带状疱疹瘢痕外)、关节等其他系统受累表现。外院自身免疫性抗体阴性,肺泡灌洗液检出多种细菌序列。结合患者既往发生严重带状疱疹、育龄期,需考虑患者有无自身免疫受损合并特殊病原体感染、自身免疫性疾病累及肺部的可能。根据患者的病情,主要考虑以下疾病:
1、感染性疾病: 如肺隐球菌病、肺结核等可表现为双肺多发结节性病变,病程可相对较长,起病隐匿、进展缓慢。
2、可累及肺脏且表现为双肺多发结节样病变的非感染性疾病: (1)肉芽肿性多血管炎:可累及多系统,病初常见发热等症状,多数患者上呼吸道最先受累,最常累及肺脏、肾脏,胸部影像学表现多样化,双肺结节伴或不伴空洞形成最为典型。(2)结节病:结节病为全身性疾病,肺、淋巴结、皮肤等均可受累。常表现为双侧肺门、纵隔多发对称性淋巴结肿大,不融合,可伴有肺内网格、结节状或片状阴影。疾病活动进展期可有发热、体重减轻等全身表现,血检验可见血沉增快、血钙升高、血清血管紧张素转化酶(sACE)升高等。
团队认为,下一步需完善血常规、尿常规、痰涂片+培养、肝肾功能、电解质、血沉、乳胶凝集试验、结核感染T细胞检测、自身免疫性抗体全套、血管紧张素转化酶进一步明确有无感染、肉芽肿性多血管炎、结节病等证据。同时需完善免疫球蛋白、淋巴细胞亚群、HIV等明确患者有无免疫受损的证据。鉴于患者双肺结节病灶靠近外周,病灶相对较小,且外院已行气管镜检查、肺泡灌洗及二代测序,均未见阳性发现,故拟行胸部增强CT及CT引导下肺穿刺,进一步明确病灶性质。
11月5日,患者于我院实验室及辅助检查情况如下:
胸部CT平扫+增强三维:1、双肺多发结节,突出病灶位于右肺下叶外基底段和左肺下叶前基底段。2、纵隔淋巴结肿大。3、肝脏钙化灶。4、右肾结石。5、脾大。双肺多发实性结节、玻璃结节,最大者位于右肺下叶外基底段(IM177),长径约1.7cm,边缘浅分叶,周围多发毛刺,内见含气支气管影。纵隔内可见数枚肿大的淋巴结。心脏大小未见明显异常,心包未见明显积液。双侧胸腔未见积液,胸膜未见增厚。肝内斑点状致密影,右肾结节状致密影,脾脏体积增大。


图7:胸部CT平扫+增强三维(2020/11/5)
11月9日进行血液检查: 白细胞:2.4×10^9/L↓、中性粒细胞%:61.4%、淋巴细胞%:23.0%、单核细胞%:9.9%、嗜酸性粒细胞%:5.3%、嗜碱性粒细胞%:0.4%、中性粒细胞:1.47×10^9/L↓、淋巴细胞:0.55×10^9/L↓、单核细胞:0.24×10^9/L、嗜酸性粒细胞:0.13×10^9/L、嗜碱性粒细胞:0.01×10^9/L、红细胞:3.93×10^12/L、血红蛋白:110g/L↓、平均血红蛋白量:28.0pg、平均血红蛋白浓度:327g/L、有核红细胞计数:0%、有核红细胞绝对值:0×10^9/L、血小板:102×10^9/L↓、超敏C反应蛋白:9.58mg/L;
常规生化: 总蛋白:56.6g/L↓、白蛋白:42.4g/L、球蛋白:14g/L↓、白球比:2.99↑、前白蛋白:225mg/L↓、丙氨酸氨基转移酶:15U/L、天门冬氨酸氨基转移酶:23U/L、γ谷氨酰基转移酶:24U/L、乳酸脱氢酶:321U/L↑、葡萄糖:5.8mmol/L、尿素:4.8mmol/L、尿酸:316umol/L、肌酐:64umol/L、碱性磷酸酶(AKP):100U/L、钾:3.53mmol/L、钠:143mmol/L、氯:107mmol/L、钙:2.16mmol/L、估算肾小球滤过率:106ml/min;
凝血系列: 正常对照时间:13.3、凝血酶原时间:13.0S、INR:1.00、活化部分凝血活酶时间:37.9S、纤维蛋白原:2.32g/L、凝血酶时间:14.5S、D-二聚体:1.17ug/ml↑、FDP:2.4mg/L;
免疫球蛋白: 补体C3:0.816g/L、补体C4:0.303g/L;
甲功性激素: T3:2.54nmol/L、T4:133.00nmol/L、FT3:5.59pmol/L、FT4:15.52pmol/L、超敏TSH:5.94mIU/L↑;(2020/11/9)血沉检测: 红细胞沉降率:5mm/h;
特定蛋白IgG4:0.0030g/L↓;
乙肝系列: 乙肝表面抗原:阴性━COI、乙肝表面抗体:阴性━IU/L、乙肝e抗原:阴性━PEIU/ml、乙肝e抗体:阴性━COI、乙肝核心抗体:阴性━Index;
内毒素/D: 真菌D-葡聚糖检测:133.7↑;
病原系列: 丙肝抗体★:阴性━、梅毒特异性抗体:阴性━、梅毒血清反应素TRUST:阴性━、HIV抗体初筛:阴性━;
11月10日,常规生化: 血管紧张素转化酶:31.4U/L;
11日,结核感染T细胞检测:阴性;
T淋巴细胞亚群: NK:19.0、NK绝对值计数:169、CD3:77.7%、CD3绝对值计数:690、CD4:47.3%、CD4绝对值计数:420、CD8:27.8%、CD8绝对值计数:247、CD4/CD8:1.70%;
12日,痰一般细菌涂片:G+球菌 (4+);痰真菌涂片:未找到孢子和菌丝;痰结核涂片: 抗酸染色镜检未查见抗酸杆菌;
13日,PCT/B12/FO: 叶酸:20.10nmol/L、维生素B12:760.00pmol/L;
14日,痰真菌培养: 培养2天无酵母菌生长:菌;
16日,痰普通培养: 金黄色葡萄球菌、青霉素:耐药ug/ml、苯唑西林:敏感ug/ml、庆大霉素:敏感ug/ml、左氧沙星:耐药ug/ml、红霉素:耐药ug/ml、克林霉素:耐药ug/ml、利奈唑胺:敏感ug/ml、万古霉素:敏感ug/ml、利福平:敏感ug/ml、复方新诺明:敏感ug/ml、磷霉素:mm;
20日,尿常规无异常;粪常规+隐血无异常。
患者收入我科后,自5日到20日以来,一般情况良好,无发热,予头孢他啶、利奈唑胺抗感染治疗后,咳嗽、咳痰明显好转。
根据现有检查结果,团队将如何进一步讨论患者的可能病因?还需要完善哪些检查措施?从后续补充的检查结果中,能判定病因吗?而当我们从肺结节穿刺病理得出结论后,再回顾患者长达半年余时间的病程,纷繁复杂的检查结果中,是否有线索一直被我们忽视呢?下一期我们将继续为您揭秘,《结节病样的病变、肝脏和肺肉芽肿浸润、不同程度ACE水平增高……可判定结节病吗?为何这两种情况下应评估CVID?丨疑案探密(45)》,敬请期待!
专家介绍

唐昊
上海长征医院(海军军医大学第二附属医院)呼吸与危重症医学科主任,中华医学会呼吸病学分会 9/10届青委会委员,中国医师协会呼吸医师分会青年委员,上海市医学会呼吸病学分会委员,上海市医学会呼吸病学分会哮喘学组副组长,上海市医师协会呼吸医师分会委员,上海市优秀学术带头人,上海市曙光学者,上海市浦江人才,上海市科技启明星。

方正
上海长征医院(海军军医大学第二附属医院)呼吸与危重症医学科副主任医师、副教授,上海市医学会呼吸分会委员,上海市医学会呼吸分会感染学组委员,上海市黄浦区专家组成员。从事呼吸内科工作30多年,擅长肺癌的早期诊断和综合诊治、肺部疑难和危重感染的诊治、慢阻肺和哮喘的治疗,支气管镜的介入治疗、胸膜疾病的胸腔镜诊治等。获*队军**科技进步二、三等奖各1项。承担国家重大专项基金1项、国家自然科学基金2项、上海市科委基金1项。发表论文30多篇,其中SCI收录8篇;主编专著1部。

宋慧慧
上海长征医院(海军军医大学第二附属医院)呼吸与危重症医学科主治医师、硕士,PCCM 2017级学员。发表科研论文4篇,其中SCI文章2篇,国内核心论文1篇,参与2项国家自然科学基金、1项国家青年科学基金,参与编写专著1本。
本文完
采写编辑:冬雪凝
头条排版:Lisa